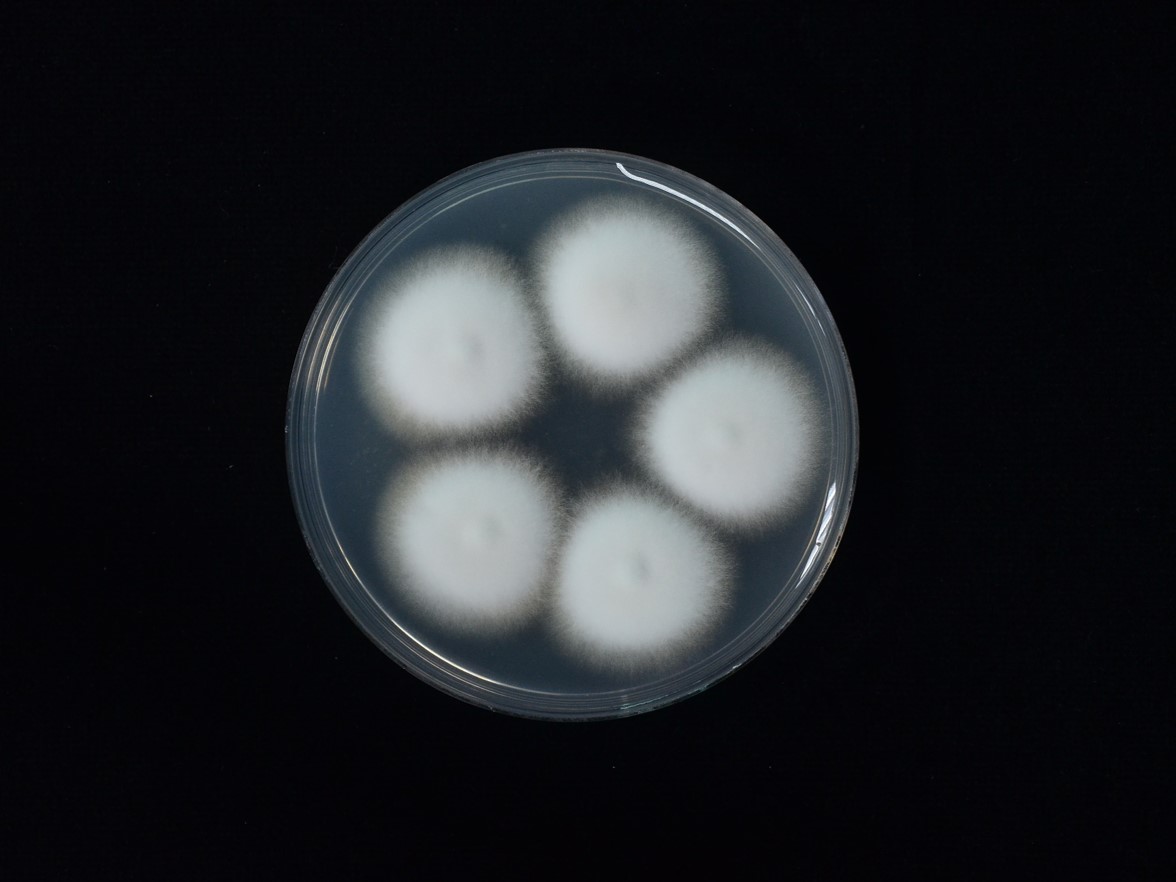

Holotype:
THAILAND, Nakhon Ratchasima Province, Khao Yai National Park, 20 Jun. 2012, K. Tasanathai, S. Mongkolsamrit, A. Khonsanit, W. Noisripoom, P. Srikitikulchai, K. Sansatchanon, R. Somnuk, holotype BBH 35749, ex-type living culture BCC 53604.
Habitat:
Underside of a dicotyledonous leaf.
Host:
On Cebrenninus cf. magnus (Thomisidae, Araneae).
Description:
 Synnema arising from white to cream mycelial mat completely covering the
Synnema arising from white to cream mycelial mat completely covering the  spider host, cylindric, white to cream, slightly enlarged toward the sterile tip, consisting of multiseptate somewhat loosely bound longitudinal hyphae.
spider host, cylindric, white to cream, slightly enlarged toward the sterile tip, consisting of multiseptate somewhat loosely bound longitudinal hyphae.  Conidiophores scattered, arising from a network of hyphae loosely attached to the surface of the synnema, occasionally from a mycelium covering the host, 45–150 × 5–8 µm, verrucose, multiseptate, tapering abruptly to a short distinct neck, enlarging into a broadly ellipsoid to globose vesicle, 4.5–8.5 µm in diam. Metulae borne on vesicle, broadly obovoid to obovoid, 5–9 × 3–6.5 µm, bearing a group of narrowly obovoid phialides, thickened towards papillate apices, 4–9 × 1.5–3.5 µm. Vesicle, metulae and phialides forming spherical heads, 23–33.5 µm in diam.
Conidiophores scattered, arising from a network of hyphae loosely attached to the surface of the synnema, occasionally from a mycelium covering the host, 45–150 × 5–8 µm, verrucose, multiseptate, tapering abruptly to a short distinct neck, enlarging into a broadly ellipsoid to globose vesicle, 4.5–8.5 µm in diam. Metulae borne on vesicle, broadly obovoid to obovoid, 5–9 × 3–6.5 µm, bearing a group of narrowly obovoid phialides, thickened towards papillate apices, 4–9 × 1.5–3.5 µm. Vesicle, metulae and phialides forming spherical heads, 23–33.5 µm in diam.  Conidia fusiform, 4–9 × 1.5–3.5 µm.
Conidia fusiform, 4–9 × 1.5–3.5 µm.  Perithecia developed on subiculum of the host, arranged sparingly, occasionally crowded, superficial with a loose covering of cream mycelia, reddish yellow, ovoid, 1,150–1,411 × 375–575 µm.
Perithecia developed on subiculum of the host, arranged sparingly, occasionally crowded, superficial with a loose covering of cream mycelia, reddish yellow, ovoid, 1,150–1,411 × 375–575 µm.  Asci over 600 µm long, 3.5–6 µm wide, ascus cap, 6–10 × 3.5–5 µm. Ascospores bacilliform, multiseptate, whole, over 570 µm long, 1–1.5 µm wide.
Asci over 600 µm long, 3.5–6 µm wide, ascus cap, 6–10 × 3.5–5 µm. Ascospores bacilliform, multiseptate, whole, over 570 µm long, 1–1.5 µm wide.  Granulomanus-like asexual morph often occurring on the mycelial mat covering the host body. Polyblastic and irregularly shaped phialides developing multiple denticles, each bearing filiform conidium, 6–12 × 1–1.5 µm.
Granulomanus-like asexual morph often occurring on the mycelial mat covering the host body. Polyblastic and irregularly shaped phialides developing multiple denticles, each bearing filiform conidium, 6–12 × 1–1.5 µm.
Culture characteristics:
Colonies on PDA slow-growing, attaining a diam of 1.5 cm in 4 weeks at 25 °C, white, velvety; reverse cream, becoming light brown with age toward center.
Colonies on PDA slow-growing, attaining a diam of 1.5 cm in 4 weeks at 25 °C, white, velvety; reverse cream, becoming light brown with age toward center.
Reference:
Kuephadungphan W, Tasanathai K, Petcharad B, et al. (2020). Phylogeny- and morphology-based recognition of new species in the spider-parasitic genus Gibellula (Hypocreales, Cordycipitaceae) from Thailand. MycoKeys72: 17–42.
DOI: https://doi.org/10.3897/mycokeys.72.55088Species |
Strain |
Compound |
Pubchem CID |
Biological activity |
Reference |
|---|
|
Strain |
ITS | LSU | RPB1 | RPB2 | TEF1 |
|---|---|---|---|---|---|
| BCC 32072 | MT477067 | - | - | - | MT503326 |
| BCC 39705 | MH532874 | MH394673 | MH521895 | MH521859 | MH521895 |
| BCC 53551 | MT477068 | - | - | - | MT503327 |
| BCC 53604 | MT477069 | MT477062 | MT503321 | MT503336 | MT503328 |